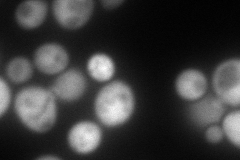
YPR060C
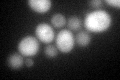
YPR060C
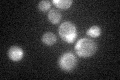
YPR060C

View description
Chorismate mutase, catalyzes the conversion of chorismate to prephenate to initiate the tyrosine/phenylalanine-specific branch of aromatic amino acid biosynthesis
Localization:
Intensity:
Fold change:
Significance:
-
C’ GFP library in SD

cytosol68.63 -
N' NOP1pr-GFP in SD

cytosol152.737 -
N' TEF2pr-mCherry in SD
cytosol171.846 -
N' NATIVEpr-GFP in SD

cytosol45.3613 -
N' TEF2pr-VC and Cyto-VN in SD

cytosol54.3438 -
C’ GFP library in SD+DTT
cytosol45.830.66No -
C’ GFP library in SD+H2O2

cytosol69.541.01No -
C’ GFP library in Starvation Media
cytosol34.940.5No -
C’ GFP library on the background of Pup2-DaMP

cytosol -
C’ GFP library on the background of CCT mutant

cytosol61.5190.8963No
